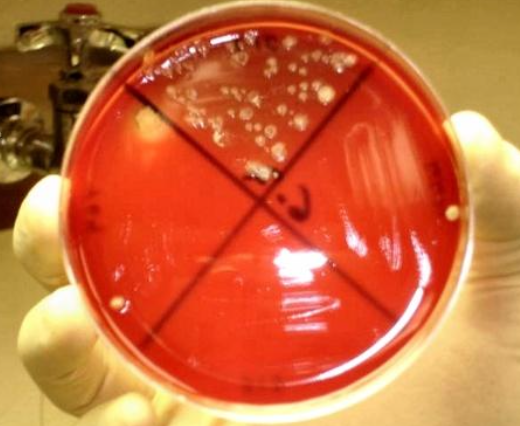
<p>1. e. coli (usually early infections)</p><p>2. f. necrophorum (more common 3-7 days post calving)</p><p>3. t. pyogenes (more chronic infections)</p><p>4. bacteroides</p>

1/64
Looks like no tags are added yet.
Name | Mastery | Learn | Test | Matching | Spaced |
|---|
No study sessions yet.
what is the importance of uterine disease in the cow?
uterine diseases are major problems in dairy farming and cause long-term economic losses
reproductive performance is the main reason for culling
what are risk factors for uterine diseases?
1. decreased immune system
2. metabolic causes
3. environmental contamination
4. herd stressors
5. calving management

what are causes of immune suppression in the cow that occur at the time of calving?
-cortisol release from calving
-negative energy balance
-increasing estrogen

what metabolic conditions are associated with increased risk of a cow developing uterine disease?
negative energy balance:
1. reduced dry matter intake
2. hypocalcemia
3. hyperketonemia

how does reduced dry matter intake (DMI) increase a cows risk for developing uterine disease?
increases susceptibility to infections

how does hypocalcemia increase a cows risk for developing uterine infections?
impairs immune cell response including neutrophil function
lower Ca++ in mitochondria decreases use as secondary messenger and decreases release of cytokines and impaired neutrophil funtion

how does hyperketonemia increase a cows risk for developing uterine infections?
high concentrations of ketone bodies and fatty acids impair function of neutrophils

what stressors/hormonal changes can increase risks of cows developing uterine disease?
-herd dynamics (taking away/adding animals)
-handling practices
-management of calving pens

what calving issues increase the risk of a cow developing uterine disease?
stillbirth
twinning
retained placenta
c-section

what is the structure of the bovine placentome?
'finger in glove' fit
interdigitation of caruncle and cotyledon provides large surface area to provide nutritional and oxidative exchanges between fetus and maternal circulations

what is the process of normal separation of the placenta from the caruncle?
1. collagenase secreted by placenta weakens the mechanical link between uterus and placenta
2. uterine contraction and compression loosen and begin separation of placenta
3. shrinking of cotyledons as blood drains form placenta allows placenta to slip out of uterine caruncle

what are general causes of retained placentas in cows?
mechanical, inflammatory, or bad timing can lead to edema formation that locks placenta in place

what is the pathophysiology of retained placentas?
-persists until necrosis of placenta allowing it to detach
-leukocytes migrating from caruncles to devitalized placenta hasten necrosis

what is the definition of retained fetal membranes (RFM)?
failure to pass fetal membranes within 24 hours after calving (failure of cotyledons to separate from caruncles)

what is the incidence of RFM in dairy cattle?
5-15%

what are consequences of RFMs?
-hyperketonemia
-metritis
-endometritis
-increased risk of pyometra
-mastitis
-decreased milk production
-reduced fertility

what are causes of RFMs?
1. calving issues (twinning, stillbirth, premature, uterine torsion, hydrops, c-section)
2. nutritional deficiencies (Ca2+, selenium, vitE)
3. immune function (neutrophil function, decreased IL-8)
4. reduced hormones levels at calving (oxytocin, PGF2a)
5. infectious causes
6. season
7. genetics

what are clinical signs of RFMs?
-fetal membranes present from vulva
-tenesmus
-fetid odor

what is the management/treatment of RFMs?
most will separate (rot out) and fall out after 3-12 days after calving
high risk of developing metritis (important to do daily physical exams)

when should cows with RFMs be treated?
treat when the cow becomes systemically ill (metritis)

what treatments are not effective for RFMs in cows?
oxytocin, PGF2A, manual removal of RFMs

what is metritis?
inflammation of all layers of the uterus within 21 days of calving (most occur within 3-10 days after calving)
it is a polymicrobial postpartum uterine disease

what is the incidence of metritis in dairy cattle?
15-40%

what can metritis lead to?
-impaired repro performance
-increased pregnancy losses (EED)
-anovulation
-increased calving-to-conception interval
-produce less milk in early lactation
-increased risk of culling

what is the average cost of metritis in cows?
$267-410 per case
untreated can lead to additional $250 in profit losses

what are the clinical signs of metritis in cows?
-history of RFM
-clinical signs within 21 days of calving
-foul smelling, red-brown uterine discharge
-endotoxemia (systemic illness)

what are clinical signs of endotoxemia in cows caused by metritis?
fever
elevated heart rate
inappetence
dull

how is metritis in cows diagnosed?
TPRR
rectal exam
metricheck

what rectal exam findings will be seen in cows with metritis?
-abnormally enlarged uterus
-flaccid uterus
-phyometra
-gental raking may extrude brown-red, foul smelling discharge
-pain on palpation

what are the classifications of metritis?
grade 1
grade 2
grade 3

what is grade 1 metritis?
no signs of systemic illness or fever
what is grade 2 metritis?
acute puerperal metritis
fever, reduction in appetite, decreased milk production, prolonged resting periods

what is grade 3 metritis?
toxic metritis/septicemic
recumbent and showing signs of toxemia

what bacteria commonly cause metritis?
1. e. coli (usually early infections)
2. f. necrophorum (more common 3-7 days post calving)
3. t. pyogenes (more chronic infections)
4. bacteroides
what is the treatment for metritis? (no toxemia)
systemic antibiotics
what is the treatment for metritis and toxemia?
antibiotics
fluid therapy
NSAIDs (flunixin)
what antibiotics can be used to treat metritis?
1. beta-lactams (penicillin): gram +/-, anaerobes
2. cephalosporins (ceftiofur): gram +/-, anaerobes
3. tetracyclines: gram +/-, anaerobes

A randomized controlled trial evaluating ____ administration for metritis therapy found that ____ chance of cure with the treatment meaning more milk and better chance of getting pregnant. No difference in ___ or ___.
- ceftiofurĀ
- better
- pregnancy or culling

what is the expected outcome of metritis with treatment?
-absence of fever in 2-6 days after treatment
-absence of fetid discharge
-no difference in production parameters
what about nonantibiotic treatments for metritis?
some evidence to support intrauterine dextrose (sugar) as a drawing agent to draw out/plasmolyze bacteriaĀ
what is endometritis?
endometrial inflammation that does not expand past the stratum spongiosum
>5% neutrophils on cytology
what is the incidence of endometritis in dairy cattle?
20-50%
how is endometritis diagnosed?
cytobrush or low volume uterine lavage
-determine number of neutrophils
what is purulent vaginal discharge (PVD)?
purulent or mucopurulent vaginal discharge (>50% pus in discharge)
15-30% incidence in dairy cattle

how is purulent vaginal discharge (PVD) diagnosed?
-metricheck
-enlarged cervical diameters (>7.5 cm)
-cervicitis
-visual/clinical detection

Endometritis is a ___ disease, while purulent vaginal discharge has ___ detection.
subclincial - endometritis
visual/clincial - purulent vaginal discharge
is endometritis always caused by bacterial pathogens?
not always associated with bacterial infection, can be from local inflammation
what can endometritis lead to?
reproductive issues and pregnancy loss

what is the cause of PVD?
bacterial infections:
-T. pyogenes or streptococci
-causes changes in the microbiotia of uterus

what can PVD turn into?
PVD can turn into endometritis
which can then lead to reproductive issues and pregnancy loss

what are consequences of endometritis/PVD?
-reduced conception rates due to inflammation of endometrium
-chronic endometritis can lead to endometrial scarring
-obstruction of oviducts
-adhesions between ovary and bursa

how is ultrasound used to diagnose PVD?
will see PVD week 5 post-calving
sensitivity=85%, specificity 51%

how is ultrasound used to diagnose endometritis?
will see endometritis week 5 post-calving
sensitivity=72%, specificity 49%

why is PGF2-alpha used to treat endometritis and PVD?
-induces luteolysis and decreases progesterone and its immunosuppressive effect
-increase estrogen levels during onset of estrus stimulates uterine contractility and clearance of uterine contents
ā no improvement of pregnancy rates
is PGF2-alpha more effective in treating endometritis or PVD?
better for endometritis (has lesser effect on PVD)
are antibiotics effective in treating endometritis/PVD?
systemic antibiotics show no improvement as they have low concentration levels in the endometrium
endometritis has no difference in microbiota from normal cows
In Canada, ___ antibiotics may be considered for endometritis/PVD but oxytetracycline can cause ___ and penicillin has ____.
intrauterine,
necrosis, several resistant strainsĀ
what is pyometra?
accumulation of purulent material within the lumen of the uterus in the presence of a persistent CL and a closed cervix
infection of the oviducts can occur influencing fertility

how is pyometra differentiated from PVD?
in PVD, there may or may not be a CL and the cervix allows drainage of pus

what are complications of pyometra?
-cant get pregnant
-abnormal uterine environment
-bacteria modulate PGF secretion
-ovarian growth and development is inhibited

how is pyometra diagnosed?
palpation and U/S
-no fetus
-no placentomes
-visualize flocculant material

what is the treatment for pyometra?
PGF2-alpha

why is PGF2alpha used to treat pyometra?
PGF2alpha will open the cervix, and cause contractions allowing pus to drain
usually multiple injections required (2 injections 14 days apart)

what are the treatment outcomes of pyometra?
-long term cases are challenging (longer than 2 months= lesser chances of getting pregnant)
-can lead to endometrial damage

what about antibiotics or estradiol for pyometra?
- abx - you tell me ā not really helpful unless long-term pyometra that has now developed infection up to oviducts, opening cervix is typically enough
- estradiol - controversial, drug use laws, possible oviductal infection/inflammation